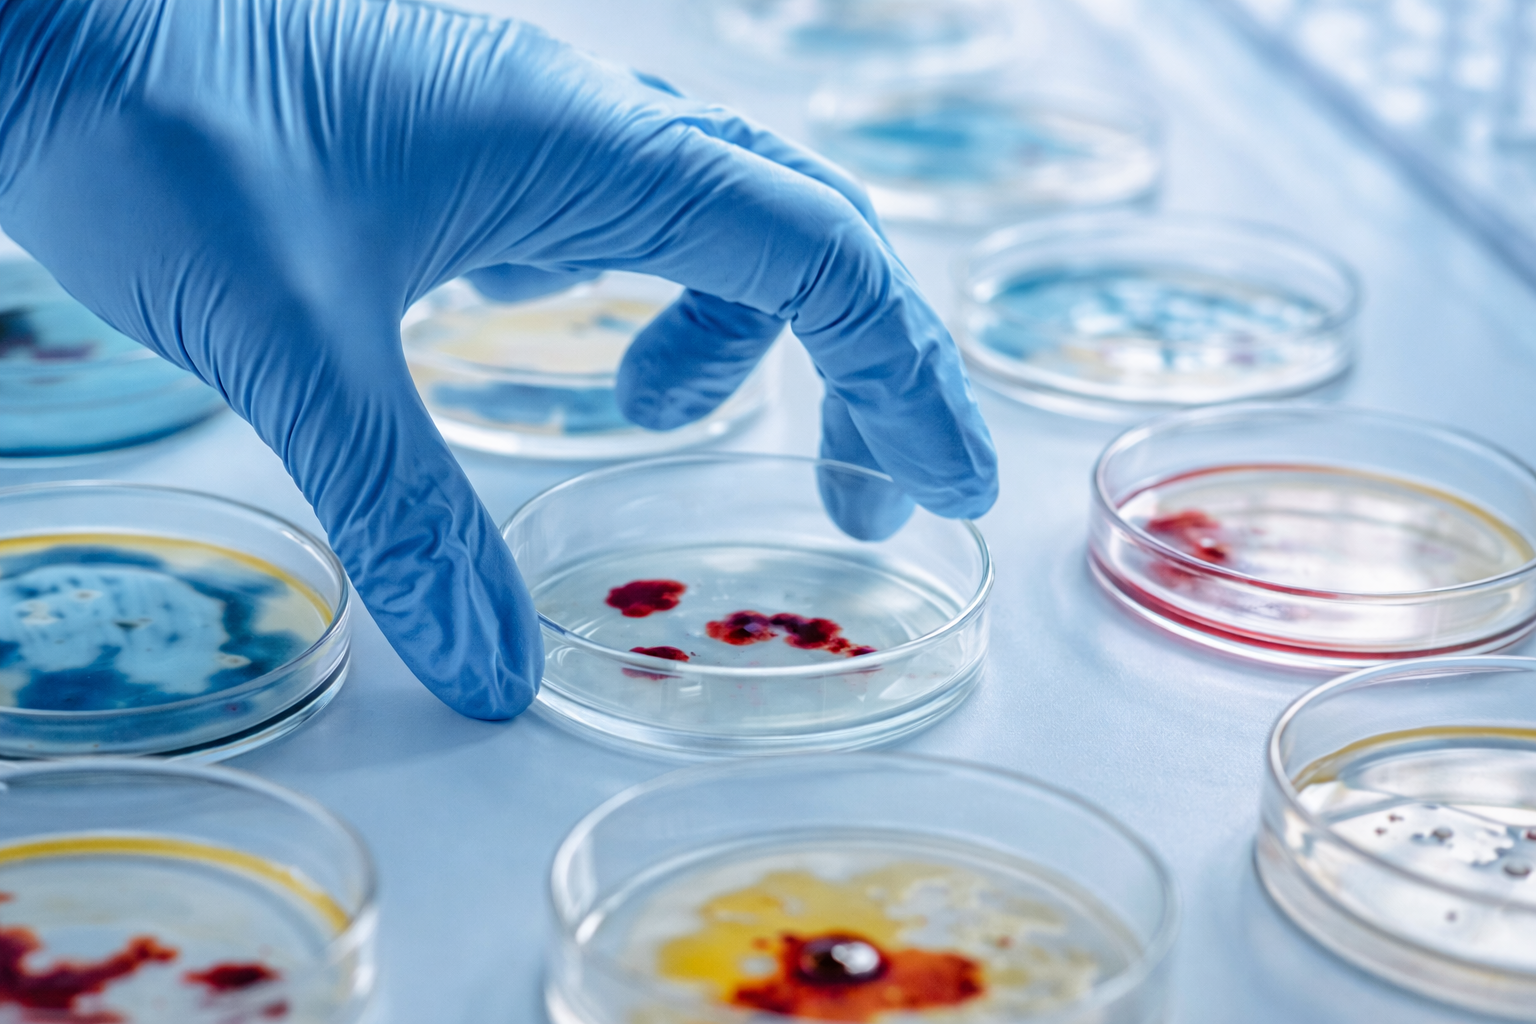

Trusted Chemical Solutions for Critical Operations
A UAE-based trading partner delivering quality chemicals and laboratory supplies with consistency, safety, and long-term reliability.
KMECO International – Trusted Trading Solutions
KMECO is a UAE-based trading company dedicated to supporting laboratories, industries, healthcare providers, and educational institutions with reliable chemical and laboratory solutions. Operating from the Ajman Free Zone, we focus on delivering quality products with clarity, compliance, and consistency.
We were established to simplify sourcing for essential chemicals, equipment, and consumables while maintaining responsible trade practices. Our team understands the importance of accuracy, safety, and uninterrupted supply, and we work closely with our clients to ensure their daily operations run smoothly.
At KMECO International, we believe strong partnerships are built through transparency, dependable service, and long-term commitment.
Simplifying sourcing with reliable, compliant, and on-time supply solutions.
At KMECO, our services are built around one simple idea: make sourcing easy and dependable. We handle the complexity of procurement so our clients can stay focused on their work, confident that their supplies will arrive on time and in full compliance.

Chemical Import and Export Services
Regulated import and export of chemicals, ensuring safe handling, compliance, and efficient cross-border supply.

Laboratory & Medical Equipment Supply
Reliable laboratory and medical equipment selected to support accurate testing, research, and diagnostics.

Laboratory Glassware & Plasticware
Precision-engineered glassware and plasticware designed for safety, durability, and consistent laboratory performance.

Safety Products & Protective Solutions
Essential safety and protective solutions that help laboratories and facilities maintain compliance and safeguard personnel.

Laboratory & Medical Consumables
Consistent supply of daily-use laboratory and medical consumables to support uninterrupted operations.
Microbiological Testing Support Services
Specialized media and products that enable accurate microbiological testing in controlled environments.
Industries We Support with Tailored Solutions
We support a diverse range of sectors with reliable, compliant sourcing solutions, ensuring every industry we serve operates smoothly, efficiently, and without interruption.
Why KMECO INTERNATIONAL
Purpose-built expertise, regulatory assurance, and dependable supply delivered through one trusted partner, enabling uninterrupted operations across critical industries.
Specialized Expertise
Strong chemical and laboratory knowledge for precise, reliable sourcing.
Compliance Assured
Fully aligned with UAE regulations to ensure safe and compliant operations.
One Trusted Partner
A single source offering a wide and dependable product range.
Steady Supply Flow
Reliable availability that keeps your operations running without disruption.
Stay Connected With Our Latest Updates.
A trusted trading partner delivering chemical and laboratory solutions with precision, reliability, and commitment across industries.
Quick Links
Contact Us
- Phone: +971 55 3723879
- Phone: +971 54 2671639
- mail:peter@kmecointl.com
- Address:Office - C1 - SF13887 AJMAN FREE ZONE UNITED ARAB EMIRATES
